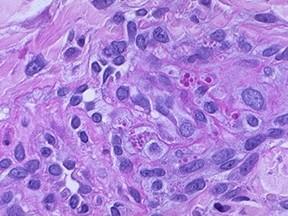
Kaposi水痘樣疹

概述
Kaposi水痘樣疹
Kaposi水痘樣疹皰疹樣濕疹(Eczema Herpeticum)於1845年由Kaposi提出,又稱Kaposi水痘樣疹,種痘性濕疹及柯薩奇濕疹等名稱。指在原有的皮膚病基礎上感染單純皰疹病毒或牛痘病毒而發生的一種皮膚病。 發生於5歲以內的兒童,亦可見於成人。感染單純皰疹病毒後,經5d~9d潛伏期,突然出現高熱、全身不適、噁心、嘔吐等中毒症狀;皮疹開始於面部、頸、上肢及軀幹等原有皮膚局部,也可以發生在正常皮膚上,下肢少見。
病因
兒童、營養不良者及免疫功能低下者對HSV易感,當患有某些基礎皮膚病,如特應性皮炎、濕疹、燒傷、毛囊角化病、皮膚大皰性疾病、魚鱗病樣紅皮病或其他炎症性皮膚病,再與單純皰疹患者直接接觸,是誘發本病的重要因素。
飲食因素(30%):
食物方面常見的有魚、蝦等,吸入方面的如花粉、塵蟎、羊毛等,微生物如體表化膿性球菌和淺表真菌的感染,生活環境中的如日光、炎熱、乾燥,各種動物皮毛、皮屑,及各種化學物質如化妝品、肥皂、合成纖維等。
個體因素(25%):
如慢性感染病灶、慢性膽囊炎、扁桃體炎、腸寄生蟲,內分泌及代謝改變方面如月經周期、妊娠等因素,血循環障礙常見的如小腿靜脈曲張誘發小腿濕疹,神經精神因素與本病的發生也有密切關係,如精神緊張及過度疲勞等。
疾病因素(20%):
在同一環境和條件,有些人易發濕疹而另一些人則不發病。而有些因素,在一定條件下,可使患者病情加重,而在其他情況下又不引起疾病再發。根據臨床表現、發病過程和組織病理所見,有些患者的發病機制可能與遲髮型變態反應有關。
臨床表現
多見於3歲以內的嬰幼兒,亦可見於成人。潛伏期5~9天,突然出現高熱、全身不適、噁心、嘔吐、嗜睡等中毒症狀,次日即發疹。表現為原皮損加重,其上見水皰與膿皰,皰頂中央有臍窩狀凹陷,基底周圍紅暈。經8~14天皮疹漸乾燥結痂,留有色素沉著及淺表性瘢痕,全身症狀亦隨之消失。併發症有咽炎、扁桃體炎、中耳炎、結膜炎、角膜炎、支氣管炎、肺炎或其他繼發感染。
並發病症
通常繼發於體質低下,或長期使用免疫抑制劑以及有灰指甲等真菌感染的患者,如並發細菌感染可有發熱、皮膚腫脹、破潰及膿性分泌物流出等表現。嚴重病例可導致膿毒血症,故應引起臨床醫生的注意。
相關檢查
1.血常規: 白細胞減少。
2.用Tzanck細胞學檢查法 :皰底塗片可見有巨細胞。
3.組織病理 :表皮內或表皮下可見水皰或膿皰,有網狀變性和氣球變性,常有多核上皮細胞,真皮有大量炎細胞浸潤,以中性白細胞為主,基底層細胞原漿內有Guarnieri小體(牛痘病毒包涵體)。
診斷
根據臨床表現及有單純皰疹接觸史可確診。
鑑別診斷
本病需與牛痘性濕疹相鑑別,兩病臨床不易區別,但後者有種痘或接觸種痘的歷史,組織病理檢查基底層細胞胞漿內有Guarnier小體(牛痘病毒包涵體)。
治療
(一)內服藥療法 :目的在於抗炎、止癢。常用的有抗組胺藥、鎮靜安定劑。急性期可選用鈣劑、維生素C、硫代硫酸鈉靜脈注射,或用普魯卡因靜脈封閉。對用多種療法效果不明顯的急性泛發性濕疹患者,可考慮短期使用皮質類固醇,一旦急性症狀被控制後即應酌情減量撤除,以防長期使用激素引起的不良反應。有感染時應考慮加用抗生素。
(二)局部療法:對症選用適當的劑型,外用藥物應根據需要及皮疹特點,選用清潔、止癢、抗菌、抗炎、收斂及角質促成劑等。
疾病護理
 Kaposi水痘樣疹
Kaposi水痘樣疹患有特應性皮炎等炎症性皮膚病的兒童,應避免與單純皰疹患者接觸,發病後立即隔離,以免傳染他人。對其用具與衣物亦應消毒(煮沸或曝曬)。
1.有濕疹、異位性皮炎等皮膚病患兒,應避免接觸單純皰疹病人。
2.發病後及時隔離,臥床休息、多飲水,多吃營養豐富、易消化的食物。加強護理。

